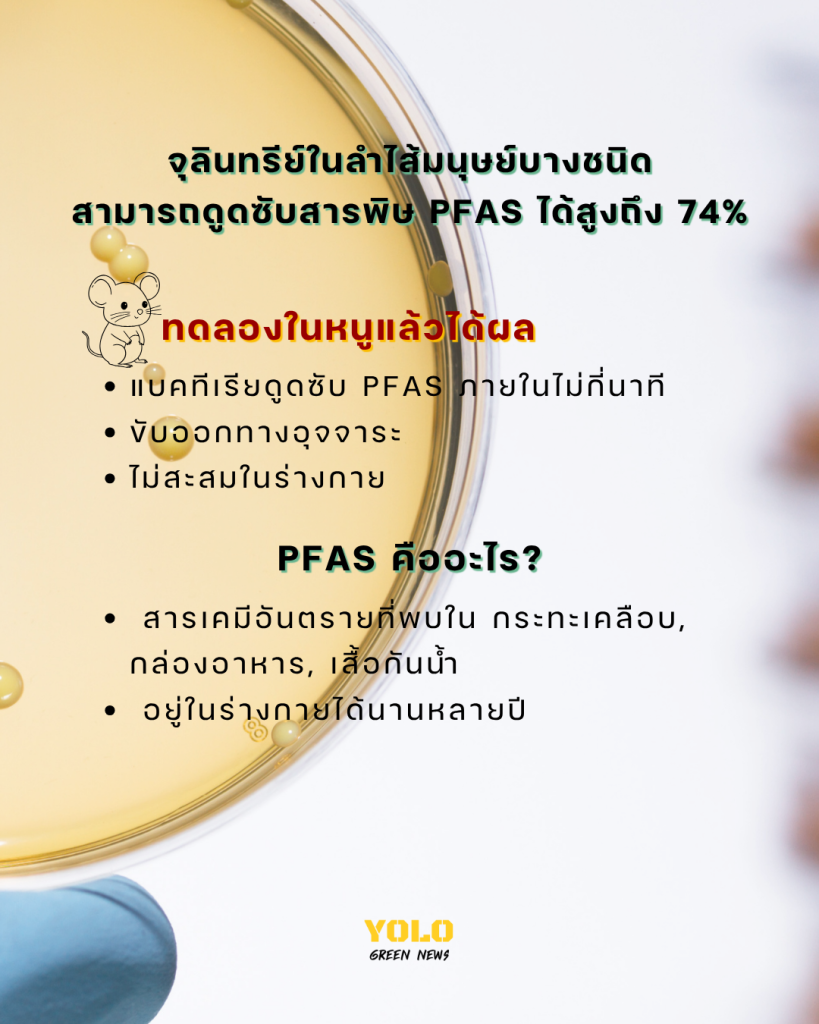

นักวิจัยจากมหาวิทยาลัยเคมบริดจ์ค้นพบว่าแบคทีเรียบางชนิดในลำไส้มนุษย์สามารถดูดซับสาร PFAS (สารเคมี “ชั่วนิรันดร์” ที่พบในของใช้ประจำวัน เช่น กระทะเคลือบสารกันติดและบรรจุภัณฑ์อาหาร) ได้อย่างมีประสิทธิภาพ โดยทดลองในหนูและพบว่าแบคทีเรียเหล่านี้สามารถดูดซับ PFAS ได้ถึง 25–74% ภายในไม่กี่นาที และขับออกทางอุจจาระ ถือเป็นหลักฐานแรกที่บ่งชี้ว่าไมโครไบโอมในลำไส้อาจมีบทบาทในการช่วยกำจัดสารพิษชนิดนี้ออกจากร่างกาย
ทีมวิจัยเตรียมพัฒนา “โปรไบโอติก” อาหารเสริมที่มีจุลินทรีย์ช่วยดูดซับ PFAS เพื่อป้องกันผลกระทบต่อสุขภาพ เช่น ภาวะมีบุตรยาก ปัญหาพัฒนาการ และโรคมะเร็ง ขณะนี้ยังไม่ทดลองในมนุษย์โดยตรง แต่ถือเป็นความหวังใหม่ในการลดสารพิษสะสมในร่างกาย โดยระหว่างนี้ แนะนำให้หลีกเลี่ยงภาชนะเคลือบ PFAS และใช้เครื่องกรองน้ำคุณภาพดีเพื่อลดความเสี่ยง
ที่มา : https://phys.org
#สิ่งแวดล้อม #ข่าวต่างประเทศ #yologreennews #พลาสติก #pfas